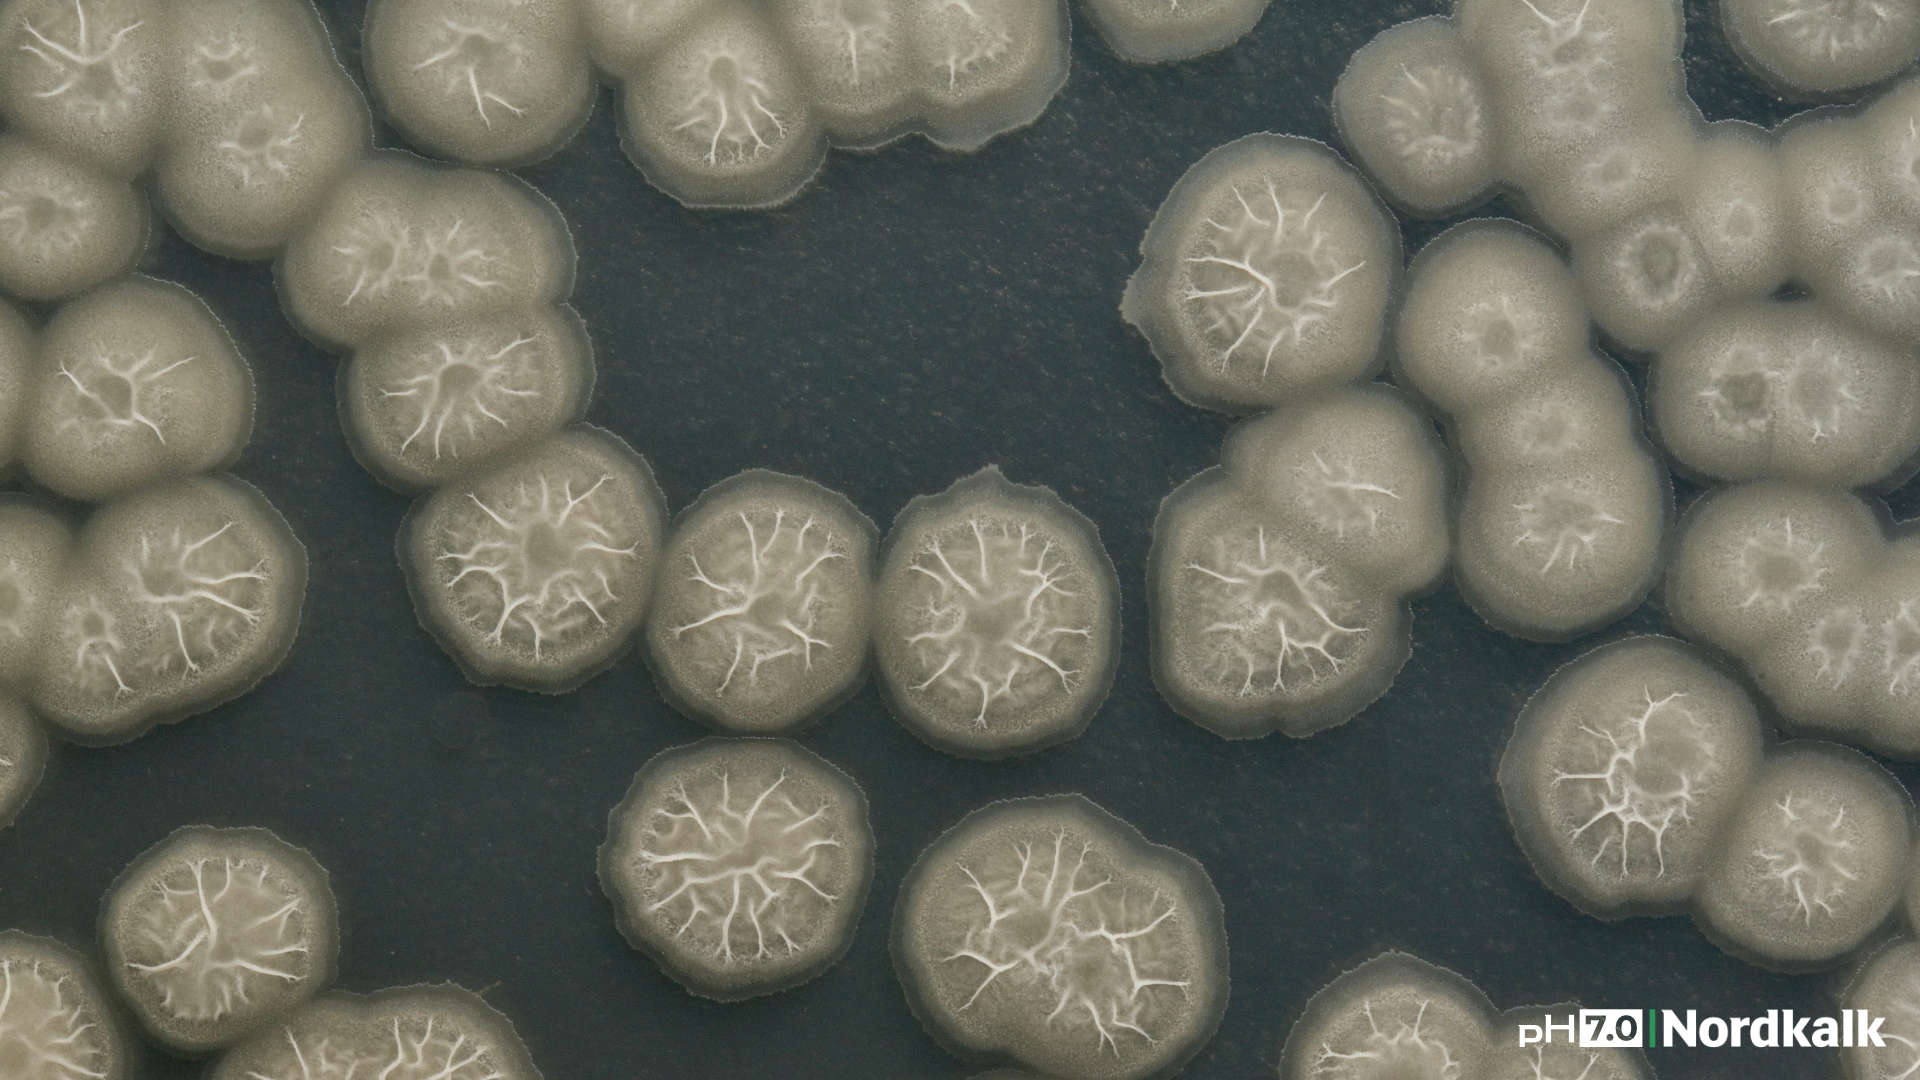

Melasa w glebie – jak wpływa na mikrobiom i skuteczność wapnowania?
Żyzność gleby w ogromnym stopniu zależy od aktywności mikroorganizmów. To właśnie bakterie, grzyby i promieniowce odpowiadają za rozkład materii organicznej, przemiany składników pokarmowych oraz tworzenie stabilnej struktury gleby. Coraz częściej mówi się więc, że skuteczna agrotechnika powinna wspierać nie tylko rośliny, ale również życie biologiczne gleby. Jednym ze sposobów pobudzania mikrobiomu jest dostarczanie łatwo przyswajalnego węgla organicznego – na przykład w postaci melasy. Jak wpływa ona na mikroorganizmy glebowe i dlaczego jej połączenie z wapniem może zwiększać skuteczność wapnowania? Na to pytanie odpowiem w dzisiejszym wpisie.
Szacuje się, że w jednym gramie żyznej gleby może znajdować się nawet kilka miliardów mikroorganizmów. Ich aktywność w dużej mierze decyduje o tym, jak efektywnie rośliny są w stanie pobierać składniki pokarmowe.
Mikroorganizmy glebowe – niewidzialni sprzymierzeńcy roślin
Mikrobiom glebowy pełni wiele kluczowych funkcji, o czym w filmie „Na Ratunek Glebie” więcej mówiła Pani prof. dr hab. Alicja Niewiadomska. Czyniąc jednak dłuższą historię krótszą warto podkreślić kilka najważniejszych kwestii: mineralizuje materię organiczną, udostępnia roślinom składniki pokarmowe, uczestniczy w obiegu azotu, fosforu czy siarki. Mikroorganizmy są również odpowiedzialne za stabilizację struktury gleby oraz ciągłe wsparcie rozwoju systemu korzeniowego.
Bez aktywnego życia biologicznego gleba staje się środowiskiem znacznie mniej produktywnym. Nawet wysoki poziom nawożenia mineralnego nie jest w stanie w pełni zastąpić procesów biologicznych zachodzących w glebie.
W środowisku glebowym funkcjonują różne strategie życiowe mikroorganizmów. Część z nich – tzw. kopiotrofy – rozwija się bardzo szybko w obecności łatwo dostępnych źródeł węgla i odpowiada za intensywną mineralizację materii organicznej. Inne, określane jako oligotrofy, są przystosowane do życia w środowisku ubogim w składniki pokarmowe i uczestniczą w procesach humifikacji, czyli budowie trwałych związków próchnicznych. Zachowanie równowagi między tymi grupami mikroorganizmów jest jednym z kluczowych elementów stabilności biologicznej gleby.
Bacillus subtilis – jedna z najbardziej znanych bakterii glebowych. Uczestniczy w rozkładzie materii organicznej.
Odczyn gleby – pierwszy krok do aktywnego mikrobiomu
Jednym z najważniejszych czynników wpływających na aktywność mikroorganizmów jest pH gleby. Większość bakterii glebowych najlepiej rozwija się w środowisku lekko kwaśnym lub zbliżonym do obojętnego. W glebach silnie zakwaszonych aktywność biologiczna gwałtownie spada. Dominować zaczynają wówczas organizmy przystosowane do trudniejszych warunków, a wiele korzystnych procesów biologicznych ulega spowolnieniu.
Dlatego regulacja odczynu gleby poprzez wapnowanie jest jednym z podstawowych zabiegów poprawiających warunki funkcjonowania mikrobiomu glebowego. Jednak samo podniesienie pH nie zawsze wystarcza, aby pobudzić intensywną aktywność biologiczną gleby…
Mikroorganizmy potrzebują energii – czyli rola węgla w glebie
Aby mikroorganizmy mogły się rozwijać, potrzebują źródła energii. Tym źródłem jest przede wszystkim węgiel organiczny. W naturalnych warunkach pochodzi on głównie z resztek pożniwnych, korzeni roślin oraz materii organicznej w glebie. Jednak zdarza się, że dostępność łatwo przyswajalnego węgla może być ograniczona. Dotyczy to szczególnie gleb ubogich w materię organiczną lub stanowisk, na których resztki roślinne są intensywnie rozkładane.
W takich warunkach dodatkowe źródło łatwo dostępnych związków węgla może silnie pobudzić aktywność mikroorganizmów glebowych. Jednym z takich naturalnych źródeł energii dla mikrobiomu jest właśnie melasa.
Melasa – naturalna pożywka dla mikroorganizmów
Melasa jest produktem ubocznym przemysłu cukrowniczego i zawiera duże ilości łatwo przyswajalnych związków organicznych. Jej podstawowym składnikiem jest sacharoza, która może stanowić około 50% składu melasy. Oprócz tego zawiera ona liczne substancje biologicznie czynne, takie jak:
- aminokwasy,
- witaminy,
- związki organiczne o działaniu fizjologicznym,
- makro- i mikroelementy (m.in. potas, żelazo, wapń, magnez, fosfor i siarkę).
Wiele z tych pierwiastków występuje w formach łatwo przyswajalnych, często związanych w postaci naturalnych kompleksów organicznych.
Po wprowadzeniu melasy do gleby zawarte w niej cukry są bardzo szybko wykorzystywane przez mikroorganizmy. W pierwszych godzinach po aplikacji obserwuje się często gwałtowny wzrost aktywności mikrobiologicznej, który prowadzi do intensyfikacji procesów biologicznych w glebie.
Jak melasa wpływa na mikrobiom glebowy?
Dodatek melasy do gleby może powodować kilka istotnych zmian w środowisku glebowym. W pierwszej kolejności przyspiesza mineralizacja materii organicznej, czyli rozkład związków organicznych do prostszych form mineralnych dostępnych dla roślin. Jednocześnie rozwój biomasy mikroorganizmów oraz obecność bardziej złożonych resztek organicznych (np. słomy) sprzyja procesom humifikacji i tworzeniu stabilnych związków próchnicznych.
Wzrost aktywności mikroorganizmów przekłada się także na zwiększenie aktywności enzymatycznej gleby. Enzymy produkowane przez bakterie i grzyby glebowe odgrywają kluczową rolę w rozkładzie resztek roślinnych oraz transformacji składników pokarmowych. Co więcej, łatwo dostępne cukry stanowią doskonałe źródło energii dla bakterii i grzybów glebowych. W efekcie dochodzi do zwiększenia liczebności wielu grup mikroorganizmów, w tym bakterii heterotroficznych i promieniowców.
Melasa wprowadza także dodatkową pulę węgla do gleby, co wpływa na stosunek C:N. Może to sprzyjać rozwojowi korzystnych grup mikroorganizmów oraz stabilizacji procesów biologicznych w glebie. W praktyce oznacza to, że gleba otrzymuje szybki impuls biologiczny – mikroorganizmy zaczynają intensywnie przetwarzać materię organiczną, a składniki pokarmowe szybciej przechodzą do form dostępnych dla roślin.
Wapń i mikrobiom – stabilne środowisko dla życia biologicznego
Oprócz dostępności węgla bardzo ważnym czynnikiem wpływającym na funkcjonowanie mikroorganizmów jest odczyn gleby, który w dużej mierze regulowany jest przez obecność wapnia.
Wapń z kolei wpływa na:
- stabilizację odczynu gleby,
- poprawę struktury agregatowej,
- zwiększenie porowatości gleby,
- poprawę warunków powietrzno-wodnych.
Dzięki temu w glebie powstaje środowisko sprzyjające zarówno rozwojowi mikroorganizmów, jak i systemu korzeniowego roślin. Szczególnie intensywne procesy biologiczne zachodzą w ryzosferze, czyli w bezpośrednim otoczeniu korzeni. To właśnie w tej strefie mikroorganizmy rozkładają materię organiczną i przekształcają składniki pokarmowe w formy dostępne dla roślin.
W glebie o odpowiednim odczynie bakterie i grzyby funkcjonują znacznie efektywniej, co przekłada się na intensyfikację procesów biologicznych. Połączenie stabilizującego środowisko wapnia z łatwo dostępnym źródłem węgla, jakim jest melasa, tworzy więc bardzo sprzyjające warunki dla życia biologicznego gleby – sprzyja namnażaniu mikroorganizmów, przyspiesza procesy mineralizacji oraz wspiera rozwój systemu korzeniowego roślin.

Szczególnie intensywne procesy biologiczne zachodzą w ryzosferze, czyli w bezpośrednim otoczeniu korzeni.
Co mówią badania?
Badania przeprowadzone w 2025 roku w Katedrze Gleboznawstwa i Mikrobiologii Uniwersytetu Przyrodniczego w Poznaniu wykazały, że zastosowanie wapna z dodatkiem melasy może istotnie wpływać na aktywność biologiczną gleby.
W doświadczeniu obserwowano m.in.:
- wzrost liczebności bakterii,
- wzrost liczebności promieniowców i grzybów,
- zwiększenie aktywności biochemicznej gleby.
Biologiczny wskaźnik żyzności gleby wzrósł średnio o 49% po zastosowaniu wapna z melasą. Jeszcze wyraźniejszy efekt obserwowano w wariancie, w którym wapno z melasą stosowano wraz z pozostawioną słomą – wówczas wzrost wskaźnika żyzności osiągał nawet 72%. Oznacza to, że połączenie wapnowania z dodatkiem łatwo dostępnego węgla organicznego może wyraźnie zwiększać aktywność mikrobiologiczną gleby.
W badaniach zaobserwowano również wyraźny wzrost liczebności mikrobiomu autochtonicznego gleby. W wariancie z wapnem i melasą liczebność mikroorganizmów była ponad dziewięciokrotnie wyższa niż w próbie kontrolnej, natomiast w wariancie z dodatkiem słomy wzrost ten przekraczał dziewiętnastokrotność wartości wyjściowej.
AtriGran – wapń wspierający życie biologiczne gleby
Przykładem takiego rozwiązania jest wapno granulowane Nordkalk AtriGran, w którym węglan wapnia połączono z dodatkiem melasy. Granula AtriGran składa się z reaktywnego wapienia pochodzącego ze złoża jurajskiego oraz naturalnego składnika organicznego – melasy.
W tym połączeniu:
- wapń stabilizuje odczyn gleby i poprawia warunki środowiskowe,
- melasa dostarcza mikroorganizmom łatwo przyswajalnej energii.
Dzięki temu w glebie powstaje środowisko sprzyjające zarówno rozwojowi mikroorganizmów, jak i systemu korzeniowego roślin. W efekcie gleba może szybciej odzyskiwać aktywność biologiczną, a procesy odpowiedzialne za dostępność składników pokarmowych przebiegają intensywniej.
Podsumowanie
Regulacja odczynu gleby poprzez wapnowanie pozostaje jednym z najważniejszych zabiegów agrotechnicznych. Coraz większe znaczenie zyskują jednak rozwiązania, które oprócz poprawy pH wspierają również życie biologiczne gleby. Dodatek melasy stanowi naturalne źródło energii dla mikroorganizmów glebowych i może pobudzać ich aktywność już w krótkim czasie po aplikacji.
Połączenie wapnia stabilizującego odczyn gleby z łatwo przyswajalnym węglem organicznym tworzy warunki sprzyjające rozwojowi mikrobiomu, a w konsekwencji także wzrostowi roślin i poprawie żyzności gleby.
Przeczytaj więcej
31 marca 2026
Obornik i wapnowanie – sztuka mądrego nawożenia
31 grudnia 2025
Wapnowanie zimowe – kiedy warto wykonać?
30 listopada 2025
Regeneracja gleby w praktyce – próchnica, struktura i organizmy
29 października 2025


